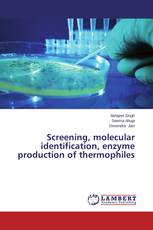
Screening, molecular identification, enzyme production of thermophiles

Biotechnology to Improve Indigenous Potato Cultivars in Bangladesh
Mohammad Mahbube Alam, M. Monzur Hossain, Md. Bulbul Ahmed - ISBN: 978-3-659-37122-6
Screening, molecular identification, enzyme production of thermophiles
Abhijeet Singh, Seema Ahuja, Devendra Jain - ISBN: 978-3-659-61574-0
Hemp fabric reinforced nanoclay–cement nanocomposites
It-Meng Low, Ahmad Hakamy, Faiz Shaikh - ISBN: 978-3-659-59202-7
Rule Conversion in Varieties of Iranian Languages:Generative Phonology
Tahereh Ezatabadi Poor, Aliyeh Kord-e Zafaranlu Kambuziya - ISBN: 978-3-659-61303-6
Personality Development
A Book for College and University Students
Peter Kibet Koech, Jane Nyaga - ISBN: 978-3-659-61568-9
Decipher the Host-Pathogen Interactions
A Computational Case Study
Hufeng Zhou - ISBN: 978-3-659-58305-6
Micro Enterprises in India
An Empirical Study of West Garo Hills District of Meghalaya
Kh. Devananda Singh - ISBN: 978-3-659-59770-1